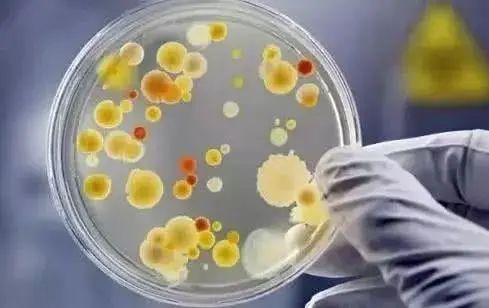
警惕冰箱里的杀手,冰箱内的腐臭味对身体有害吗

要注意"冰箱杀手",发臭还致癌!开水烫不死,要放个"蛋"才能解决
天气愈来愈热,许多人将家中的冰箱视为万能百宝箱,剩菜、罐头食物,甚至冰淇淋与饮料,吃剩下的、喝不完的,统统放进冰箱。

食物放冰箱,真的不会坏吗?
冰箱中可能暗藏哪一些容易忽略的细菌杀手?放在冰箱中的食物,应该如何分类冷藏保鲜,做好冰箱管理,才不会愈冰细菌愈多?

6成人食物放冰箱放到过期坏掉,冰箱可以说比马桶还脏!
曾经有教学医院针对某地区所进行的《食物冷藏保鲜观念调查》结果显示,近6成人常将冰箱里的食物放到过期坏掉,导致冰箱成为家中堆放过期食物与滋生细菌的大本营,冰箱可以说比马桶还脏!
专家表示,冰箱只是暂时保存,并没有杀菌的功能,一旦使用不当,往往会变成细菌繁殖箱!从冰箱散发出的异味,就是细菌代谢产生的硫化氢、甲基胺等气体。

食材若没有适当的保存,可能会有霉菌污染的问题,而最常见的就是黄曲毒素及赭曲霉菌:
1、黄曲毒素:第一级致癌物
黄曲毒素是世界卫生组织认定的第一级致癌物。一般人认为只有发霉的花生与其制品中才有黄曲毒素,其实不然,例如:五谷杂粮、坚果类、豆类、南北干货类、辛香料、腌渍类食品;都因为没有真空包装,或开封后没有妥善保存,都难逃黄曲毒素生长的污染。

2、赭曲毒素:2B类致癌物
赭曲毒素是由于谷物保存不当的状况下,导致霉菌大量生长而产生的毒素。建议选购谷物时,真空包装是首选,或者选择完全干燥且包装完整的产品。开封后也要注意食品保存,不要放太久,储存环境避免潮湿,尽量将食品与空气中的水气隔绝。

有些网友会问,吃剩下的饭菜直接用盘子装,然后放冰箱好吗?
常见许多家庭主妇都是将三餐吃剩的饭菜直接装在盘子里,摆进放冰箱,甚至空间不够还一层层地堆栈菜盘子,挤在冰箱狭小的空间里。

这样做的风险,在于冰箱被塞爆无法呼吸,其实冰箱放食物的空间最好不要超过7成,否则很容易滋生细菌。
一旦感染上这些细菌,轻则出现发烧、肌肉疼痛,恶心、腹泻等症状,重则导致颈部僵硬、身体失衡,痉挛等后果。
还有,如果你一打开冰箱就闻到异味,这说明冰箱细菌已经严重超标了;你就得注意冰箱的卫生问题,因为异味就是细菌代谢产生的。

要想吃得健康,关键还是得冰箱杀菌去异味,从根本上解决食物保鲜和异味问题!那要选择什么来杜绝这种情况?
今天小编就得给大家推荐日本黑科技发明 小黄鸡硅藻除味蛋,杀菌祛味双效合一!

这款除味蛋能够祛除异味
还能有效杀菌
在冰箱里放一颗
不但刺鼻的臭味被吸得干干净净
而且危害健康的细菌也通通被杀死
同时也能当干燥剂
干燥空气

1、优选上等硅藻土,匠心制造
这款除味蛋由北海道天然硅藻土制成
来自日本北海道的硅藻遗骸
经过数十亿年的不断沉积
形成了表面具有无数密孔的硅藻土
纯天然,不含异味和有害物质
人们称它为“会呼吸的活化石”

科学研究证明
硅藻土对甲醛等有害气体的吸附能力
是活性炭的5000-6000倍!
空气中的有害气体
没一会就被它吸得一干二净

日本人早在几十年前
还有一大堆的硅藻土衍生品
硅藻澡盆、杯垫、浴室澡垫
食品干燥剂,专业吸附一百年
只要想吸水,吸有害气体
认准硅藻土没错了!

这款除味蛋精选天然硅藻土
另外添加活性竹炭
超强的吸附除菌能力
甩传统竹炭包好几条街
堪称除臭界的冠军

2、99%抑制细菌,李斯特菌克星
硅藻土的主要成分硅酸质
具有杀菌功能
既能祛除异味
同时又能有效杀灭大肠杆菌
李斯特菌等有害细菌

冰箱里放一颗硅藻土除味蛋
异味没有了
细菌不再滋生
就算长期不清洗也依然保持干净整洁

平时我们喜欢把新鲜食物放入冰箱
但并不能保鲜多长时间
食物没过几天就坏了
如果放进一颗除味蛋
保鲜期至少延长3倍

没放除味蛋的冰箱里的猪肉
两天就发臭了
而放了除味蛋的猪肉
放了一周还依然新鲜

水果也一样
没放除味蛋的苹果不到10天就坏了
而放了的仍然鲜嫩饱满

3、会呼吸的活化石,让异味无所遁形
日本岩崎硅藻土除臭蛋
由高达60%的硅藻土+活性炭制成
除异味能力相当于500包活性炭
适用于多个生活场所

异味在很大程度上都是由于细菌产生的
这颗除臭蛋拥有着强大的杀菌作用
细菌没了,异味的根源消失
外加其对异味有着强大的吸附力
除异味效果可以说快速且持久

冰箱中放一放
葱蒜味、鱼腥味,还有各种串味
第二天就全部消失
有了它食物随便放
再也不怕串味了

用在卫生间里除臭
连空气清新剂都不用买了
空气清新剂一段时间就用完了
它却可以使用一年之久
性价比可以说很高了

4、无惧南风天,干燥清爽一整天
岩崎硅藻蛋的吸湿能力强大
在实验中硅藻蛋一放入水中
水位线就急速下降
吸水效果惊人
冰箱中容易积水
用岩崎硅藻蛋再合适不过
水吸干净了,不仅能防止食物冻坏
还能增加冰箱的使用寿命

这款日本原料制作的小黄鸡冰箱除臭蛋,价格也不贵,原价39块钱每盒,现在活动价仅2盒才39.9块。一份快餐、一包烟的钱,就可以搞定一年的异味和家人健康保障。
快点击下面进入购买↓
【特惠2盒39.9】冰箱除味剂100g
¥39.9
购买